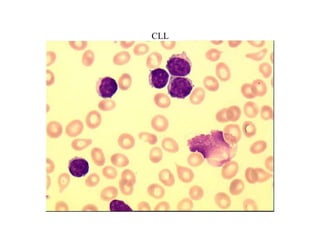
CLL

Das Dokument behandelt die verschiedenen Aspekte von Lymphomen, einschließlich Epidemiologie, Ätiologie, Pathogenese, Diagnostik, Stadieneinteilung, Prognose und Therapie. Es erläutert die verschiedenen Typen von Lymphomen, deren Häufigkeit, Risikofaktoren und therapeutische Ansätze, sowie die diagnostischen Methoden wie FACS-Analyse. Zudem werden die prognostischen Indizes für verschiedene Lymphomtypen vorgestellt.